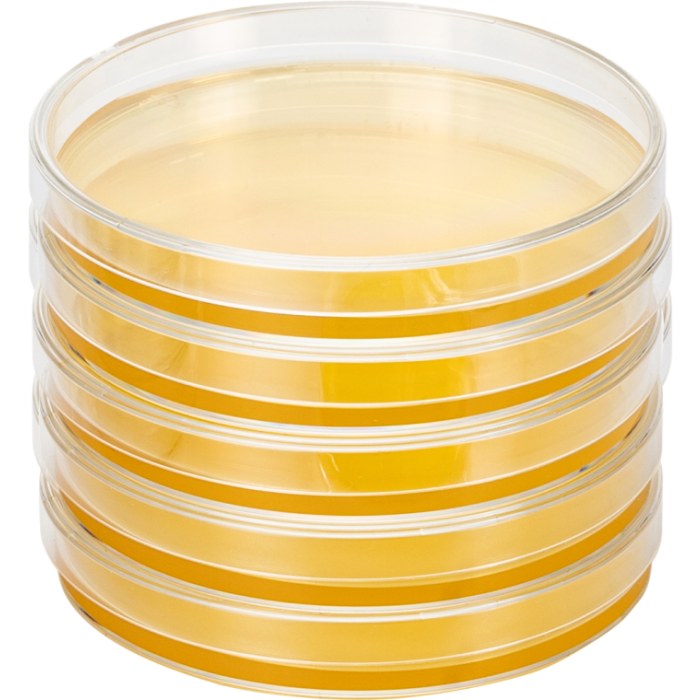

biopico LB0103 LB 琼脂平板(氨苄抗性, 50ug/mL ),90×15mm圆形板
- 销售价:
- ¥99.00
- 市场价:
-
¥99.00 - 编号:
- 202602271109132
- 货号:
- LB0103
-
累计评价
暂无评价
- 月销量: 0
- 评分数: 0
- 评分: 0.0
- 产品规格:
- 5皿/包
- 数量:
-
看了又看
推荐商品
-
 ¥598.00
¥598.00
¥598.00coolaber PM2011 YPDA Medium
-
 ¥288.00
¥288.00
¥288.00biopico YT0132 2×YT琼脂平板(无抗生素),100×100mm网格方皿
-
 ¥480.00
¥480.00
¥480.00biopico YM6301 SC-Leu Broth(液体培养基预混粉末)
-
 ¥36.00
¥36.00
¥36.00biopico 3m121 3分钟™ LB 琼脂培养基
-
 ¥5000.00
¥5000.00
¥5000.00biopico LB31G 进口琼脂(OXOID平替款)
商品介绍
产品详情:
本产品为即用型 LB 琼脂平板(含 50ug/ml Ampicillin),培养基经 121° C、20 min 高压灭菌。平板规格为 90 x 15 mm,每块平板含 20 ml 的培养基。本品适用于多种具有氨苄抗性基因细菌的生长。
产品特点:
免称量、免配制、免灭菌、免清洗。
配方成分:
| 配方(1L) | 含量 |
| 胰蛋白胨粉 | 10.0 g |
| 氯化钠 | 10.0g |
| 酵母膏粉 | 5.0g |
| 琼脂 | 15.0g |
| Ampicillin | 50 ug/mL |
存储温度:2-8℃,3 个月
订购信息:
| 货号 | 产品名称 | 产品描述 | 包装规格 |
| LB0103 | LB 琼脂平板(氨苄抗性) | LB 琼脂平板(含 50ug/mL ,Ampicillin), 90mm | 5 块 / 包 |
| LB0104 | LB 琼脂平板(氨苄抗性) | LB 琼脂平板(含 50ug/mL ,Ampicillin), 90mm | 10 块 / 包 |
注意事项:
1. 本产品仅供科学研究使用。
2. 使用前请检查平板内是否干裂或染菌,若长菌请勿使用。
3. 4°C 储存的平板出现冷凝水属正常现象,可在洁净环境下将水倒出。
4. 请在洁净环境下操作,开封后请尽快使用,避免杂菌干扰,影响您的实验。
商品参数
| 商品介绍 | |
|---|---|
| 单位 | 包 |
| 品牌 | biopico/皮米 |
商品评论
暂无商品评论信息
商品咨询
暂无商品咨询信息